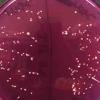

| ||||
Differential & Selective Growth Agar - P2
You have free access to a large collection of materials used in a college-level introductory microbiology course. The Virtual Microbiology Classroom provides a wide range of free educational resources including PowerPoint Lectures, Study Guides, Review Questions and Practice Test Questions.
Media Both Selective & Differential
Some specialized media are both selective and differential, others are either or. The MacConkey’s and Mannitol Salt described above are both selective and differential bacterial growth media.
In addition to MacConkey’s agar only growing Gram-negative bacteria (the selective aspect of the medium), MAC has special additives that cause lactose fermenting bacteria (microbes that can
metabolize the sugar lactose) to grow in pink colonies, whereas Gram-negative non-lactose fermenting bacteria will grow in colorless colonies.
Mannitol Salt is also both selective and differential. This medium only grows salt-loving bacteria (so it is selective). In addition, bacteria that grow on MSA that can ferment mannitol, a sugar alcohol, will turn the medium from its original pink color to a bright, neon yellow.
Sources and Resources
- Bauman, R. (2014) Microbiology With Diseases By Taxonomy, 4th ed., Pearson Benjamin Cummings.
- Bacterial Growth Media & Cultures Lab Exercise Main Page from the Virtual Microbiology Classroom
- Differential Media from the Virtual Interactive Bacteriology Laboratory.
- Schauer, Cynthia (2009) Applied Microbiology HCR120 Laboratory Manual, Kalamazoo Valley Community College.
1. Sterile plate of MacConkey's Agar (MAC); 2, LAC- Salmonella on left, LAC+ E. coli on right, both plates are MAC; 3. Happy LAC+ microbe on MAC; 4. Lac+, Gram- microbe growing on MAC, 5. Colony directly under word "MacConkey's" os a colorless non-lactose fermenter. Click here for more MacConkey's Agar Images.
1. Sterile plate of Mannitol Salt Agar (MSA), 2. Staphylococcus epidermidis growing on MSA, 3 Mannitol + bacteria on left plate, Mannitol - bacteria on right plate, both plates are MSA; 4. Mannitol + bacteria on left, Mannitol - bacteria on right, both plated together on one MSA plate; 5. Same plate from bottom. Click here for more Mannitol Salt Agar Images.
VIDEO: How to Interpret MacConkey's Agar (MAC)
Bacterial Growth Medium
SPO VIRTUAL CLASSROOMS
PAGE 2 < Back to Page 1
Table Summarizing Selective & Differential Properties of Specialized Bacterial Growth Media
Click here for a blank printout of this table.
SCIENCE PHOTOS
SCIENCE VIDEOS
Page last updated:
8/2015
The SPO website is best viewed in Microsoft Explorer, Google Chrome or Apple Safari.
This color change is clinically significant in that Staphylococcus aureus, a disease-causing bacterium, is a mannitol fermenter, while S. epidermidis, a beneficial bacteria that normally grows on the surface of the skin and mucous membranes, is not a mannitol fermenter.